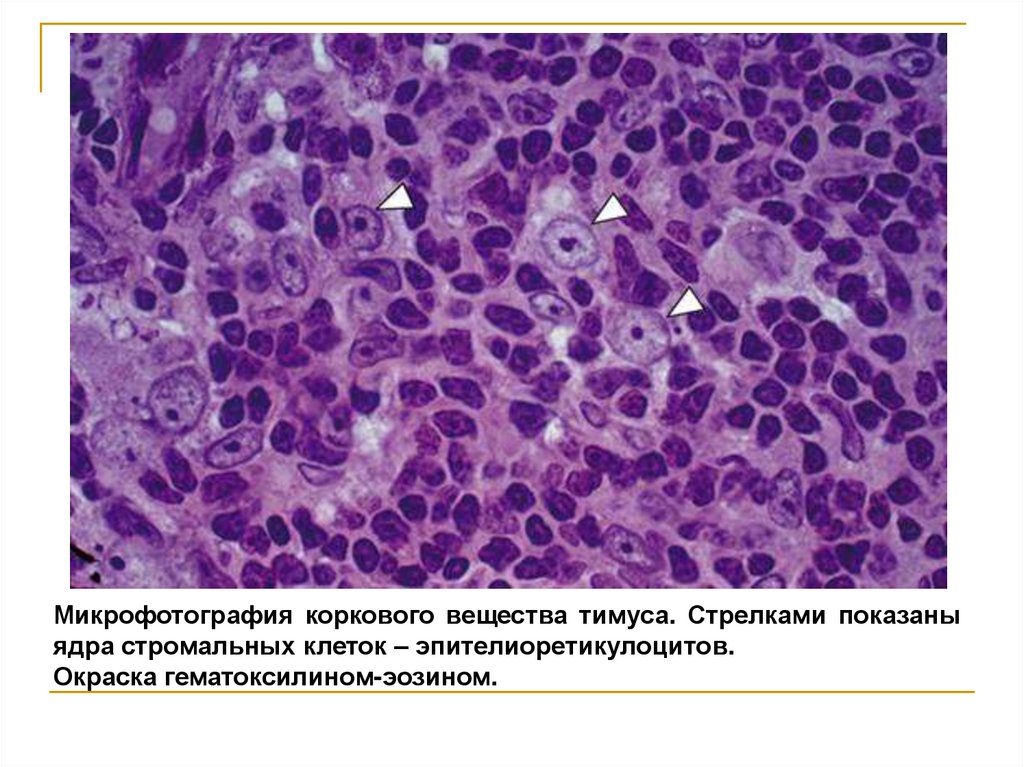

Similar presentations:
Иммунная система
1.
Тема лекции:2.
Иммунная системаСовокупность
органов,
тканей
и
клеток,
обеспечивающая иммунитет – защиту организма
от живых тел и веществ, несущих на себе
признаки генетически отличной, чем у данного
организма (чужеродной), информации.
3.
Функции иммунной системы:1) кроветворная;
2) кроверазрушающая;
3) интегративная и регуляторная;
4) поддержание иммунного гомеостаза;
5) барьерно-защитная;
6)
регуляция деления
регенерации тканей.
и
апоптоза
клеток,
4.
Органы иммунной системы делятся на:центральные
периферические
- красный костный мозг,
- тимус
железа)
- лимфатические узлы,
- селезенка,
(вилочковая - гемолимфатические узлы
- лимфоидные структуры слизистых
оболочек пищеварительного тракта,
половой,
дыхательной
и
выделительной систем
В
центральных
органах В периферических органах происходит
лимфоциты
проходят антигензависимая дифференцировка
антигеннезависимую
после встречи с антигеном.
дифференцировку,
т.е.
приобретают рецепторы для
встречи с антигеном.
5.
Иммунокомпетентные(иммуноциты)
иммунном
–
ответе
клетки
клетки,
(Т-
участвующие
и
в
В-лимфоциты,
макрофаги).
Иммунный ответ – совокупность процессов,
происходящих в иммунной системе в ответ на
введение антигена.
6. Основные понятия
Комплемент – группа белков (в сыворотке крови), котораяактивизируется при связывании антитела с антигеном,
Приводит к образованию опсонинов, которые облегчают
фагоцитоз и лизис.
На всех клетках имеются антигены гистосовместимости
(МНС - major histocompatibility complex – главный комплекс
гистосовместимости) - гликопротеины, рецепторы, имеются на
всех клетках, узнаются Тц
МНС I – присутствует на поверхности всех ядросодержащих
клеток, презентует пептидные фрагменты собственных белков
для Т-киллеров;
МНС II – присутствует на поверхности макрофагов, дендритных
клеток, В-клеток и презентует чужеродные пептиды для Тхелперов, инициируя приобретенный иммунитет.
7.
Иммунитет– это способность организма распознавать и
обезвреживать
носителей
генетической информации.
чужеродной
8. Антиген (АГ) (от antigen = antibody-generating
- чужеродные вещества сложной органическойприроды, способные при попадании в организм
вызвать иммунные реакции (бактерии, вирусы,
паразиты, мутировавшие собственные клетки,
трансплантаты).
9.
Антигены могут проникать в организм:1) через дыхательные пути (воздушно-капельная
инфекция);
2) через ЖКТ (кишечные инфекции);
3) через неповрежденную и особенно через
поврежденную кожу;
4) через слизистые оболочки глаз, носа;
5) через слизистые мочеполовых путей;
6) через кровь.
Место проникновения возбудителя в организм
называется входными воротами инфекции.
10.
Антитела (АТ)-
вещества
белковой
(иммуноглобулины),
которые
природы
образуются
в
организме в ответ на антигены, и специфически
взаимодействуя
с
ними,
уничтожают
обеспечивая гуморальный иммунитет.
их,
11.
Антителаобразуются
плазмоцитами
и
обладают специфичностью к антигенам, т.е.
связываются только с тем антигеном, на
который выработались.
Есть несколько классов иммуноглобулинов:
Ig G, IgM, IgA, IgE, IgD.
12. Строение молекулы антитела
Вариабельные области на концах:Fab-фрагменты – антигенсвязывающие
Постоянные области:
Fc-фрагмент -связывают компоненты комплемента (рецепторы)
13. Антитела (AT)
Ig G — преобладающий класс AT , производится вбольших количествах при вторичном иммунном ответе
и защищает ткани от бактерий, вирусов и токсинов.
Циркулирует в крови и лимфе.
Ig A — обнаруживается в секретах желез (пот, слезы,
слизь, молоко, вагинальный и простатический секреты),
в слизистых оболочках, в лимфатических узлах и
селезенке.
Уровень
Ig
А
повышается
при
респираторных и кишечных инфекциях.
Ig M — находится внутри сосудов и синтезируется
плазмоцитами при первичном попадании антигена в
организм.
Ig D — является маркером В-лимфоцитов, опосредует
их созревание и специализацию.
Ig Е — взаимодействует с тучными клетками и
базофилами при действии аллергенов (пыльца
растений,
пчелиный
яд
и
др.),
моделируя
аллергическую реакцию.
14.
15. Лимфоциты
главныеклетки
иммунной
отвечают
за
специфичность
ее
системы,
и
которые
сохранение
иммунной памяти.
Лимфоциты
относятся
к
классу
лейкоцитов
составляют 20-35% от их общего числа.
и
16. Лимфоциты
Различают три основных вида:Т-лимфоциты,
В-лимфоциты,
NK-клетки, или натуральные киллеры
17. Т-лимфоциты (тимус-зависимые)
самые многочисленные (70-90%) и долгоживущие.Образовавшись в ККМ из стволовых клеток, они
мигрируют в тимус, где созревают и приобретают
иммунологические свойства.
Из тимуса лимфоциты попадают в кровоток и
заселяют специальные «Т-зоны» в лимфатических
узлах, селезенке, а также образуют скопления в других
органах организма.
18. Т-лимфоциты
Т-лимфоциты–
это
клетки,
отвечающие
клеточный и гуморальный иммунный ответ.
Среди Т-лимфоцитов выделяют виды клеток:
1) Цитотоксическая Т-клетка (Тц), или Т-киллеры (Тк)
2) Т-хелперы (Тх)
3) Т-супрессоры (Тс)
4) Т-клетки памяти
за
19.
Т-киллеры (их еще называют CD8+ Т-лимфоциты),которые подобно NK-клетке (натуральному киллеру),
выделяет белки перфорин и гранзим, что приводит к
лизису клетки-мишени.
Т-хелперы (от английского helper – помощник). Они
еще обозначаются как Th-клетки, CD4+ T-лимфоциты.
Активированные Т-хелперы продуцируют хемокины и
цитокины, участвующие в иммунном процессе.
Т-супрессоры (Ts) подавляют (супрессируют) реакции
В-лимфоцитов
и
блокируют
Т-хелперы.
Они
регулируют силу иммунного ответа, что позволяет
иммунной системе сдержанно и с умеренной силой
отвечать на раздражители.
20.
• Т-киллеры - участвуют в клеточном иммунном ответе(уничтожает
чужеродные,
а
также
собственные
мутировавшие или пораженные вирусом клетки).
• Т-хелперы (Th, от англ. help – помогать) участвуют в
регуляции клеточного и гуморального иммунного ответа
путем
секреции
биологически
активных
веществ
–
цитокинов (интерлейкинов, интерферона), которые влияют
на пролиферацию и дифференцировку других лимфоцитов.
21.
• Т-супрессоры (Ts, от англ. suppress – подавлять) –подавляют активность других клеток иммунной системы,
останавливают развитие иммунного ответа посредством
секреции цитокинов (подавляется пролиферация В-
лимфоцитов и синтез антител).
•Т-клетки памяти (Tm, от англ. memory – память) –
долгоживущие
клетки,
которые
формируются после
первой встречи с антигенами – первичного иммунного
ответа.
22. В-лимфоциты (бурсо-зависимые).
В крови количество В-лимфоцитов составляет10-30%. Среди них преобладают короткоживущие
клетки.
В ходе развития В-лимфоциты трансформируются
в плазмоциты, которые вырабатывают антитела,
осуществляя гуморальный иммунитет.
23. В-лимфоциты
В-лимфоциты – из СКК в В-зоны периферических органов,эффекторные – плазматические клетки.
Электронная микрофотография
плазмоцита
Плазмоциты производят антитела. Антитела называют иммуноглобулинами. Каждое
антитело выполняет определенную работу, чтобы защитить нас от микробов.
24. Макрофаги
фундаментальнаяроль
макрофагов
—
представление антигенов лимфоцитам. Без
этой
функции
невозможно
специфическое
распознавание чужеродного антигена.
Производят ряд медиаторов иммунных реакций
(простагландины, интерлейкины и др.) и обладают
способностью свободно перемещаться в организме.
25. Нк-клетки (натуральные киллеры)
составляют 15% от всех лимфоцитов.Нк – это большие лимфоциты (12-15 мкм), имеют
дольчатое ядро и лизосомы в цитоплазме.
Образуют первую линию защиты.
Они
уничтожают
опухолевые
инфицированные вирусами клетки.
клетки
и
26. Иммунный ответ
Потипу
взаимодействия
клеток
и
образовавшихся клеток-эффекторов принято
различать:
1)
клеточный
иммунный
ответ
эффекторные клетки –Тц (Т-киллеры)
2) гуморальный иммунный ответ –
эффекторные клетки - плазмоциты
–
27. Клеточный иммунитет
осуществляетсяТ-киллерами
(эффекторные
клетки), которые напрямую взаимодействуют с
антигенами.
Клеточный
иммунитет
формируется
при
трансплантации органов и тканей, инфицировании
вирусами, злокачественном опухолевом росте.
28. Клеточный иммунитет
Распознаваяантиген,
Т-киллеры
вступают
в
тесный контакт с ним и выделяют специфические
медиаторы (перфорин, цитолизин и др.).
Целостность
«мишеней»
(антигенов)
повреждается, происходит их разрыв и гибель.
Т-киллеры сохраняются и способны к дальнейшему
действию.
29. а. Перфорин представляет собой особый протеин. В гранулах цитотоксических лимфоцитах он находится в виде растворимого
Осмотический лизис клетки-мишени как результат воздействияна нее перфоринов, синтезированных цитотоксическими
лимфоцитами
а. Перфорин представляет собой особый протеин. В гранулах
цитотоксических лимфоцитах он находится в виде растворимого белкапредшественника.
б. Будучи секретирован Т-киллером, перфорин в течение нескольких секунд
полимеризуется в мембране клетки-мишени с образованием поры.
В результате клетка-мишень разрушается в результате осмотического лизиса.
30. Гуморальный иммунитет
- Этозащита от растворенных во внутренней среде
антигенов (АГ): продуктов жизнедеятельности бактерий,
метаболитов,
аллергенов,
токсинов,
от
введенных
ответе
лимфоциты
чужеродных сывороточных белков.
- При
гуморальном
иммунном
секретируют иммунные белки – иммуноглобулины (Ig),
или антитела (АТ).
-АТ связываются с АГ и нейтрализуют их.
31. Гуморальный иммунитет
осуществляется по принципу трехклеточной системыкооперации:
макрофаг — Т-хелпер — В-лимфоцит (плазмоцит).
32.
Первой клеткой, вступающей во взаимодействие сантигеном является макрофаг.
Макрофаг «разбирает» антигены на отдельные «блоки»
и «выставляет» их на своей поверхности, которые
распознают
Т-хелперы,
а
те,
в
свою
очередь,
активируют В-лимфоциты.
Плазмоциты
(эффекторные
клетки)
секретируют
антитела (Ig), которые связываются с антигенами и
уничтожают их.
33.
Впроцессе
образуются
гуморального
клетки
памяти,
иммунного
ответа
которые
помогают
организму противостоять при повторном заражении
теми же микроорганизмами.
Т-супрессоры контролируют активность Т-хелперов.
34.
35.
36. Лимфоцитопоэз
включает два этапа:1)
АнтигенНЕзависимая
пролиферация
и
дифференцировка лимфоцитов в тимусе и
красном костном мозге;
2)
Антигензависимая
пролиферация
и
дифференцировка лимфоцитов при встрече с
антигенами в периферической лимфоидной
ткани.
37.
ЦЕНТРАЛЬНЫЕ ОРГАНЫ КРОВЕТВОРЕНИЯАнтигеннезависимая дифференцировка и
пролиферация Т и В лимфоцитов
(встреча с антигеном исключается)
1 — красный костный мозг
(в губчатом веществе плоских костей и эпифизах
трубчатых костей; до 12—18 лет — также в диафизах
трубчатых костей)
2 — тимус (вилочковая, или зобная, железа).
38.
ПЕРИФЕРИЧЕСКИЕ ОРГАНЫ КРОВЕТВОРЕНИЯАнтигензависимая дифференцировка и
пролиферация Т и В лимфоцитов
(только после встречи с антигеном)
1. Лимфоидная ткань слизистых оболочек.
а) Глоточное лимфоидное кольцо (кольцо Пирогова)
б) в стенке тонкой кишки
в) в стенке червеобразного отростка
г)
в
стенке
воздухоносных
путей
—
бронхоассоциированная лимфоидная ткань.
2. Лимфатические узлы
3. Селезенка
39.
АнтигенНЕзависимый лимфоцитопоэзантигенНЕзависимая
пролиферация
и
дифференцировка происходит в центральных
органах
иммунитета:
Т-
лимфоцитов
в
тимусе под действием гормона тимозина и Влимфоцитов в красном костном мозге.
40.
Антигензависимый лимфоцитопоэзантигензависимая
пролиферация
и
дифференцировка Т- и В-лимфоцитов происходит
при
встрече
органах
с
антигенами
иммунитета,
при
в
периферических
этом
образуются
эффекторные клетки:
из Т-лимфоцитов
Тц, Тх, Тс, Т-лимфоциты памяти
из В-лимфоцитов
плазматические клетки, В-
лимфоциты памяти
41.
42.
ОСОБЕННОСТИ СТРОЕНИЯ КРОВЕТВОРНЫХОРГАНОВ
ГЕМОПОЭТИЧЕСКИЙ КОМПОНЕНТ
Развивающиеся форменные элементы крови
МИЕЛОИДНАЯ ТКАНЬ:
- эритроциты,
- тромбоциты,
- гранулоциты,
- моноциты
ЛИМФОИДНАЯ ТКАНЬ
- лимфоциты
43.
СТРОМАЛЬНЫЙ КОМПОНЕНТ-
РВСТ
макрофаги
антигенпрезентирующие клетки
адипоциты
ретикулярная ткань
(эпителиоретикулярная ткань - тимус)
СОСУДИСТЫЙ КОМПОНЕНТ
-
кровеносные сосуды (артерии и вены)
соматические гемокапилляры
синусоидные гемокапилляры
венозные синусы (посткапиллярные венулы)
посткапиллярные венулы с высоким
эндотелием
44.
Красный костный мозгимеет темно-красный цвет и полужидкую консистенцию.
Заполняет губчатое вещество плоских и трубчатых
костей.
Общая масса органа составляет ~ 5 % от массы тела
человека.
Стромой ККМ является ретикулярная ткань.
45.
Функции ККМВ
ККМ
происходят
все
стадии
созревания
форменных
элементов
крови:
эритроцитов,
гранулоцитов,
моноцитов,
тромбоцитов
и
В-
лимфоцитов; также образуются предшественники Тлимфоцитов.
Осуществляется
антигенНЕзависимая
пролиферация и дифференцировка В-лимфоцитов.
46.
Стромальный компонент ККМРетикулярные клетки:
• опорная функция (образуют 3-х мерную сеть, в петлях которой
развиваются форменные элементы)
• синтезируют ретикулярные волокна (коллаген III типа) и компоненты
основного аморфного вещества;
• синтезируют ростовые факторы, регулирующие процесс
кроветворения.
Адвентициальные клетки:
• покрывают 50% капилляров, сокращаясь, облегчают поступление
форменных элементов в кровоток
Эндотелиоциты капилляров:
• выделяют ростовые факторы.
Адипоциты:
• отвечают за энергообеспечение кроветворения.
Макрофаги:
• поглощают чужеродные и погибающие клетки;
• выделяют ростовые факторы;
• клетки-кормилки снабжают развивающиеся эритроциты Fe
(захватывая из кровотока ферритин).
47.
Сосудистый компонент ККМвключает как обычные сосуды микроциркуляторного
русла, так и синусоидные кровеносные капилляры.
Капилляры очень широкие, что обеспечивает замедление
кровотока.
Эндотелиоциты с фенестрами, в местах соединения
имеют щели, базальная мембрана не сплошная.
Через эти промежутки в кровь проникают созревшие
форменные элементы.
Из синусов кровь собирается в центральную венулу.
48.
Гемопоэтический компонентРазвивающиеся форменные элементы размещаются
островками
Эритропоэтический островок:
• развивающиеся эритроциты располагаются вокруг
клетки-кормилки
Гранулоцитопоэтический островок:
• гранулоциты находятся по периферии костномозговой
полости
Мегакариобласты и мегакариоциты:
• находятся рядом с капилляром, часть цитоплазмы
мегакариоцита проникает в капилляр, постепенно
отделяется и в виде кровяной пластинки (тромбоцита)
попадает в кровяное русло.
Лимфоциты и моноциты:
• развиваются вблизи сосуда.
49.
Красный костный мозг50. Вилочковая железа , или тимус
располагается в грудной полости в областипереднего средостения над сердцем.
Состоит из 2 долей в виде буквы «V», откуда
произошло второе название органа —
вилочковая железа.
51.
Развитие тимуса. Схема52. Развитие тимуса
53. Развитие тимуса
54.
Функции тимуса:1)
антигенНЕзависимая
дифференцировка
Т-
лимфоцитов;
2)
эндокринная
–
ретикулоэпителиоциты
вырабатывают тимозин, тимопоэтин, тимулин.
55.
Строение тимусаТимус - паренхиматозный дольчатый орган.
Покрыт соединительнотканной капсулой.
Разделен на дольки: в каждой дольке выделяют
корковое и мозговое вещество.
Строму
состоящая
образует
эпителиальная
ткань,
отростчатых
клеток
из
(эпителиоретикулоциты)
56. Тимус
12
4
1
1
3
1
1 – дольки; 2 - междольковая соединительная ткань (септы); 3 - корковое вещество;
4 - мозговое вещество
57.
Тимус1 - капсула;
2 - междольковая
соединительная ткань;
3 - долька:
3.1 - корковое вещество,
3.2 - мозговое вещество,
3.2.1 - тельца Гассаля,
3.2.2 - кровеносные сосуды
58.
Долька тимусакорковое вещество
мозговое вещество
59.
Виды эпителиоретикулоцитов:1) Опорные клетки – составляют каркас коркового
вещества.
Окружают
сосуды
и
участвуют
в
формировании гематотимусного барьера.
2) Секреторные клетки – продуцируют тимопоэтин,
тимозин и тимулин.
3) Клетки-няньки - выполняют трофическую функцию –
имеют в своей цитоплазме глубокие инвагинации, в
которых одновременно развиваются 10-20 Т-лимфоцитов.
60.
61.
Микрофотография коркового вещества тимуса. Стрелками показаныядра стромальных клеток – эпителиоретикулоцитов.
Окраска гематоксилином-эозином.
62.
Корковое веществосостоит из 2 зон: 1) субкапсулярной, или наружной
2) зоны глубокой коры.
В субкапсулярную зону из ККМ поступают пре-Тлимфоциты.
Они
под
воздействием
подвергаются
- бласттрансформации,
- пролиферации
- антигеннезависимой дифференцировке.
тимозина
63.
Бласттрансформация–
это
преобразование
предшественников Т-лимфоцитов в Т-лимфобласты.
Пролиферация
–
это
размножение
Т-
лимфобластов при помощи митоза.
Антигеннезависимая дифференцировка – это
дифференцировка
антигена.
Т-лимфоцитов
без
участия
64. T-лимфоциты, проходящие антигеннезависимую дифференцировку (тимоциты)
В ходе развития Т-лимфоциты проходят селекцию(отбраковку).
1. Положительная селекция (отбраковывается до 95%
тимоцитов).
2. Отрицательная (отбраковываются те лимфоциты,
которые имеют рецепторы против собственных клеток
организма).
Не прошедшие отбор тимоциты гибнут с помощью
апоптоза, либо фагоцитируются макрофагами или с
участием Т-супрессоров.
65. Гематотимусный барьер
оберегаетсозревающие
лимфоциты
от
контакта
с
антигенами, находящимися в кровотоке.
В состав гематотимусного барьера входят:
эндотелий
капилляров
с
непрерывной
базальной
мембраной,
периваскулярное пространство,
опорные эпителиоретикулоциты плоской формы и их
базальная мембрана.
66.
Мозговое веществоРасполагается в центре дольки, более светлое.
Содержит
соединительнотканную
строму,
ретикулоэпителиальную основу и лимфоциты (35% от всех лимфоцитов тимуса).
Концентрические (слоистые) тельца Гассаля –
образованы
наслоенными
эпителиоцитами.
друг
на
друга
67.
Мозговое веществоЛимфоциты
возвращаться
могут
в
циркулировать
мозговое
по
организму
вещество
и
тимуса
(рециркулирующий пул лимфоцитов).
В
мозговом
веществе
присутствуют
макрофаги
и
дендритные клетки.
Здесь
происходит
дальнейшая
дифференцировка
тимоцитов (отрицательная селекция).
Прошедшие дифференцировку Т лимфоциты поступают
в посткапиллярые венулы на границе коркового и
мозгового вещества.
68.
Тельце Гассаля в мозговом веществеВ мозговом веществе
содержатся:
1 — рециркулирующие Тлимфоциты (попадают в тимус
повторно из крови);
2 — ретикулоэпителиальные
клетки: опорные и секреторные;
3
3 — тельца Гассаля, или слоистые
эпителиальные тельца
(концентрические наслоения
эпителиоретикулоцитов).
Периодически фагоцитируются макрофагами. Секретируют цитокины.
69. Возрастная инволюция тимуса
после 20 лет происходит уменьшение размератимуса, его обратное развитие (инволюция).
В
органе уменьшается число лимфоцитов,
лимфоидная ткань замещается жировой.
70.
Акцидентальная (случайная) инволюцияУстановлено, что самые различные стрессовые
воздействия приводят к тому, что масса тимуса
уменьшается.
Происходит массовая гибель лимфоцитов.
После
окончания
стресс-факторов
тимуса вновь восстанавливается.
структура
71.
Из тимуса и ККМвыходят наивные
(девственные) Т-и В –
лимфоциты, они
готовы к встрече с
антигеном.
Мигрируют из
центральных органов
кроветворения в
периферические

medicine
medicine








